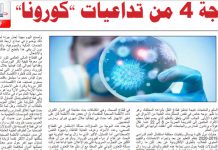
نشرة رقم عدد مايو (PDF)

كيف تفاعلت القطاعات الاجتماعية والاقتصادية مع الأزمة
قائمة المحتويات
Toggle
إن لأزمة COVID-19 تأثيراً مدمراً على جميع القطاعات الاجتماعية والاقتصادية. وقد قامت منظمة العمل الدولية في سلسلة من التقارير الموجزة، بتحليل آثار الوباء على...
274 مليار دولار خسائر قطاع النقل الجوي
في الأول من يناير 2020، كان عدد المقاعد المخطط إتاحتها خلاله أمام حركة التنقل والسفر الجوي عالميا 180 مليون مقعد، والركاب المخطط نقلهم من...
2.7 مليار عاملا يتأثرون بالأزمة
بحسب الإصدار الثالث من مرصد منظمة العمل الدولية (كوفيد-19 وعالم العمل - ILO Monitor, COVID-19 and the world of work, third edition)، فإنه من...
1.57 مليار طالبا .. تحت المطرقة
ما زالت تداعيات كوفيد-19 تتوالى محلياً وإقليمياً وعالمياً، ولا شك أن التعليم من أهم المجالات تأثراً به، في ظل وجود أكثر من مليار ونصف...
أسواق المال تفقد 30% من قيمتها تحت ضربات كورونا
في وقت مبكر من العام الحالي ، كانت الأسواق المالية مدعومة بشعور واسع من التفاؤل على خلفية السياسات النقدية الداعمة، وانخفاض التوترات التجارية، وعلامات...
الموجة 4 من تداعيات “كورونا”
عرف العالم في المرحلة اللاحقة توّاً على جائحة كورونا أو ما يُعرف علمياً بفيروس «كوفيد 19» عدة موجات من التساؤلات.
كانت الموجة الأولى أقرب إلى...